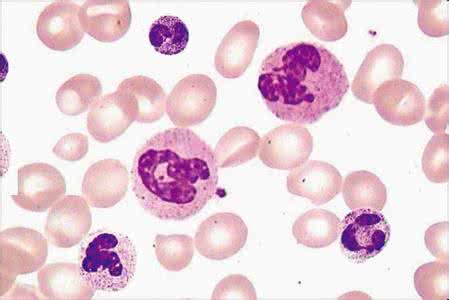
中性粒细胞百分比 中性粒细胞百分比 对中性粒细胞百分比解释

什么是中性粒细胞百分比呢,在我们生活中想必大家对于中性粒细胞也是有一定的了解的吧,那么大家知道中性粒细胞百分比偏低的原因是什么吗,中性粒细胞缺乏症是什么呢,下面就让我们一起来了解一下吧。
中性粒细胞的细胞膜不饱和脂肪酸能释放一种花生四烯酸,在酶的作用下,产生的任何进一步的由一组分泌的激素,如血栓素和前列腺素,这种物质对血管直径和通透性的调节有明显影响,可导致炎症和疼痛,和对凝血功能的影响。
中性粒细胞百分比解释
中性粒细胞(neutrophilicgranulocyte)在瑞氏(Wright)染色血涂片中,胞质呈无色或极浅的淡红色,有许多弥散分布的细小的(0.2~0.4微米)浅红或浅紫色的特有颗粒。细胞核呈杆状或2~5分叶状,叶与叶间有细丝相连。
其颗粒表面有一层膜包裹,可分1~4型,颗粒中含髓过氧化物酶(myeloperoxidase)、酸性磷酸酶、吞噬素(phagocytin)、溶菌酶、β葡糖苷酸酶、碱性磷酸酶等。中性粒细胞具趋化作用、吞噬作用和杀菌作用。
大多数颗粒细胞属于中性粒细胞。有每微升血液中性粒细胞约4500。由于这些细胞的细胞核的特殊形状,它也被称为白细胞。在只有6-8小时的时间平均血管中的中性粒细胞,他们迅速通过血管壁进入组织发挥作用,而进入组织的血液不再返回。
在血管中的中性粒细胞,约有一半随血流循环,通常作白细胞计数只反映了这部分中性粒细胞的情况;另一半则附着在小血管壁上。同时,在骨髓中尚贮备了约2.5×10(12)个成熟中性粒细胞,在机体需要时可立即动员大量这部分粒细胞进入循环血流。
中性粒细胞在血液的非特异性细胞免疫系统中起着十分重要的作用,它处于机体抵御微生物病原体,特别是在化脓性细菌入侵的第一线,当炎症发生时,它们被趋化性物质吸引到炎症部位。
由于它们是藉糖酵解获得能量,因此在肿胀并血流不畅的缺氧情况下仍能够生存,它们在这里形成细胞毒存在破坏细菌和附近组织的细胞膜。
因为嗜中性粒细胞含有大量的溶酶体酶,因此可以将吃入细胞内的细菌和组织的碎片分解,使细菌的入侵被包围在一个地方,并破坏,能防止病原微生物在体内的扩散。当中性粒细胞解体时,溶酶体酶的释放可以溶解周围组织和脓肿形成。
中性粒细胞百分比致病原理
中性粒细胞来源于骨髓的造血干细胞,在骨髓中分化发育后,进入血液或组织。在骨髓、血液和结缔组织的分布数量比是28:1:25,成年人血液中中性粒细胞的数量约占白细胞总数的55%一70%。
中性粒细胞属多形核白细胞的一种,由于其数量在粒细胞中最多,因此有人将多形核白细胞指中性粒细胞。该细胞内含许多弥散分布的细小的浅红或浅紫色的特有颗粒,颗粒中含有髓过氧化物酶、酸性磷酸酶、吞噬素、溶菌酶等。
髓过氧化物酶是中性粒细胞所特有,即使在有强吞噬作用的巨噬细胞中也极少或完全没有这种酶。在细胞化学上,一般将这种髓过氧化物酶作为中性粒细胞的标志。中性粒细胞具有很强的趋化作用。
所谓趋化作用,就是细胞向着某一化学物质刺激的方向移动。对中性粒细胞起趋化作用的物质,称为中性粒细胞趋化因子。中性粗细胞膜上有趋化因子受体,受体与趋化因子结合,激活胞膜上的钙泵,细胞向前方伸出片足,使细胞移向产生趋化因子的部位。
中性粒细胞的片足与产生趋化因子的异物接触后,接触处周围的胞质形成隆起即伪足,接触部位的细胞膜下凹,将异物包围,形成含有异物的吞噬体或吞噬泡。中性粒细胞膜表面有IgGFc受体和补体C3受体,可加速吞噬作用。
爱华网


